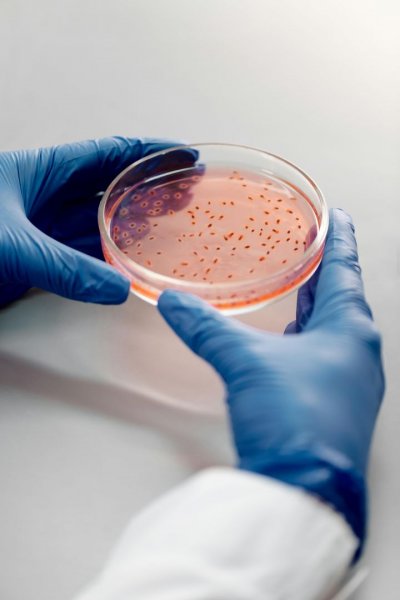

السعودية | فيروس ينتقل من الإبل إلى البشر... هل تدعو "متلازمة الشرق الأوسط" للقلق؟
طقس العرب - تسابق الوكالات الصحية الزمن لتحديد أصول تفشي فيروس "ميرس" في السعودية، إثر ظهور ثلاث حالات مؤكدة بالعدوى لدى أشخاص لم يكن لهم احتكاك مباشر مع الإبل، التي تُعد المصدر الرئيسي المعروف لهذا الفيروس، حسبما أفادت صحيفة "تلغراف" البريطانية.
الفيروس المسبب للمرض يُعرف بمتلازمة الشرق الأوسط التنفسية (ميرس)، وهو ينتمي إلى نفس عائلة فيروسات كورونا، لكنه يحمل معدل وفيات أعلى بكثير، حيث توفيت 35 بالمئة من الحالات المؤكدة، وفقا لمنظمة الصحة العالمية.
وعادةً ما ينتقل الفيروس من الإبل وحيدة السنام، وقد تم ربط معظم حالات التفشي السابقة بالأشخاص الذين يعملون على اتصال وثيق بهذه الثدييات، أو يستهلكون حليبها الخام.
ومع ذلك، لم تتمكن السلطات من ربط التفشي الحالي بالحيوانات، حيث اكتشفت الحالات الأخيرة عندما ذهب أستاذ يبلغ من العمر 56 عامًا في العاصمة الرياض إلى المستشفى في أوائل أبريل، وأثار هذا الوضع مخاوف من احتمال انتشار الحالات الأقل حدة دون اكتشافها.
أسترازينيكا تسحب لقاح كورونا من جميع أنحاء العالم... ما القصة؟
ما هي متلازمة الشرق الأوسط التنفسية؟
تُعد متلازمة الشرق الأوسط التنفسية مرضًا تنفسيًا فيروسيًا يسببه فيروس كورونا، وتم اكتشافه لأول مرة في السعودية عام 2012.
فيروس كورونا المسبب لهذه المتلازمة هو فيروس حيواني المصدر، مما يعني أنه ينتقل بين الحيوانات والبشر، وقد ثبت ارتباطه بعدوى البشر في الجِمال العربية في العديد من الدول في الشرق الأوسط وأفريقيا وجنوب آسيا.
ويؤكد الدكتور أحمد الطسة، الأخصائي في علم الوبائيات، أن متلازمة الشرق الأوسط "هي أحد أنواع فيروسات كورونا، وأصلها مثل جميع فيروسات كورونا الأخرى من الخفاش، لكنها انتقلت إلى الجمال قبل أن تصيب البشر".
ويوضح الطسة في تصريح لوسائل الإعلام، أن آخر موجة لهذه المتلازمة "كانت حادة جدًا، أكثر من كوفيد-19 الذي شهدناه"، وتسببت في نسب وفيات عالية.
وعلى الصعيد العالمي، تم الإبلاغ عن 2204 حالة و860 حالة وفاة، وفقًا لمنظمة الصحة العالمية، وسجلت الغالبية العظمى من هذه الحالات، أكثر من 80 بالمئة، في السعودية.
وتصل نسبة الوفيات بين الحالات المصابة إلى 35 بالمئة من إجمالي الإصابات التي أبلغت بها منظمة الصحة العالمية.
أسترازينيكا تعترف وتعويضات قد تصل للملايين... هل خطر لقاحها يفوق خطر مرض كورونا؟
بعد تسجيل إصابات جديدة بفيروس "متلازمة الشرق الأوسط" في السعودية، هل تدعو الحالة للقلق؟
أكدت منظمة الصحة العالمية أن هذه المستجدات لم تغير من تقييمها لخطورة الفيروس، الذي لا يزال في درجة "معتدلة" على المستويين الإقليمي والدولي.
متلازمة الشرق الأوسط التنفسية هي مرض تنفسي فيروسي يسببه فيروس كورونا، وقد اكتشف لأول مرة في السعودية عام 2012 وينتقل الفيروس بين الحيوانات والبشر، ويُرتبط بالعدوى البشرية في الجمال العربية ودول أخرى.
وفيما يتعلق بالأعراض، فتتضمن الحمى والسعال وضيق التنفس، مع احتمالية الإصابة بالتهاب رئوي. يمكن أن تصاب بالمرض دون ظهور أعراض، ولكن يُعد الانتقال بين البشر داخل المنشآت الصحية مسألة خطيرة.
وتجدر الإشارة إلى أن الصحة العالمية تعتبر الانتشار العالمي لفيروس جديد مسألة وقت، وتحث على التأهب والاستعداد للتعامل معه.
شاهد أيضا:
اعتراف "أسترازينيكا" بأن لقاح فيروس كورونا قد يسبب آثارا جانبية خطيرة.. ما القصة؟
السعودية | تعديل طقس المشاعر المقدسة في الحج... كيف ذلك؟
المصادر: